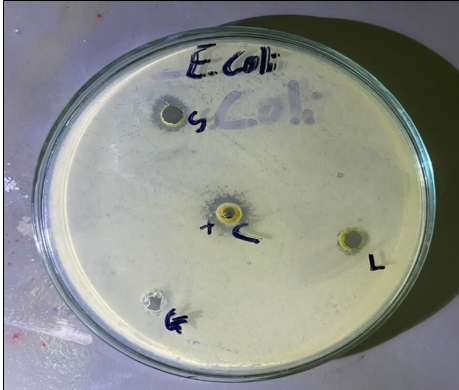

- Printed Journal
- Indexed Journal
- Refereed Journal
- Peer Reviewed Journal

Peer Reviewed Journal
Journal of Pharmacognosy and Phytochemistry
Vol. 14, Issue 6 (2025)
| S. No. | Title and Authors Name | Country |
|---|---|---|
| 1 |
Understanding Bhoomi: Ayurvedic and modern views on soil and medicine
Shreyashe Awadhkishor Nayak, Jyotsna Kulkarni and Aparna M Ghotankar
Pages: 01-03 | 138 Views 62 Downloads | Country: India
|
India |
| 2 |
Black sweet potato: A rich source of phytochemicals with therapeutic applications
Biki Islary, Dora Ponio, Lemhai Wangjen, Likha Phon, Nemcha Jugli, Raja Yangfo and Kasinam Doruk
Pages: 04-05 | 143 Views 46 Downloads | Country: India
|
India |
| 3 |
Economic viability and post- harvest challenges of organic kiwi cultivation in Ziro valley, Arunachal Pradesh
Gollo Sanjay, Soma Bori, Osinam Jamoh, Techi Nisham Tara, Talin Eyum, Kago Tada, Sushil Siongju and Kasinam Doruk
Pages: 06-08 | 165 Views 69 Downloads | Country: India
|
India |
| 4 |
Determination of bioactive compounds by flash chromatographic fractionation from Tecomella undulata (Sm.) seem and its biological applications
Joelri Michael Raj Lourdhurajan, Vasanth Nayagam, Anthony Samy and Mutheeswaran Subramanian
Pages: 09-16 | 119 Views 45 Downloads | Country: India
|
India |
| 5 |
Case study of Uttarbasti in clinical management of atonic bladder
Ganesh Uttam Asole and Gadve Babasaheb Nana
Pages: 17-19 | 130 Views 48 Downloads | Country: India
|
India |
| 6 |
Comparative analysis of Aloe vera gel, epidermis, and whole leaf extracts for antimicrobial activity
Mark Fallah
Pages: 20-29 | 369 Views 213 Downloads | Country: Sierra Leone
|
Sierra Leone |
| 7 |
Chemical screening and evaluation of the antioxidant and antibacterial activities of the phenolic content of crude bark extracts from Funtumia africana (Benth.) Stapf
Ngaïssona Paul, Namkona Frédéric Armel, Koane Jean-Noël, Worowounga Xavier, Koyakonzi Koyanzia Kenny Jonathan, Koueni Okounda Kevin Hermann, Issa-Madongo Mathurin and Syssa-Magalé Jean Laurent
Pages: 30-39 | 163 Views 64 Downloads | Country: Central African Republic
|
Central African Republic |
| 8 |
Multifaceted pharmacognostic characterization and quality assurance of Syzygium laetum, S. occidentale, and S. palghatense
Snehalatha VR and Rasmi AR
Pages: 40-46 | 168 Views 57 Downloads | Country: India
|
India |
| 9 |
Standardization of Arjuna tablet for safe and effective use
Manasi Kamble and MD Javeed Manure
Pages: 47-52 | 174 Views 63 Downloads | Country: India
|
India |
| 10 |
Syzygium travancoricum: A short review
Arthanariswaran P, Aby Augustine, Sruthi EJ, Jittu George and Anjaly TS
Pages: 53-60 | 104 Views 37 Downloads | Country: India
|
India |
Related Journal Subscription
Important Links
Important Sites
Copyright © 2012 - 2025. All Rights Reserved.